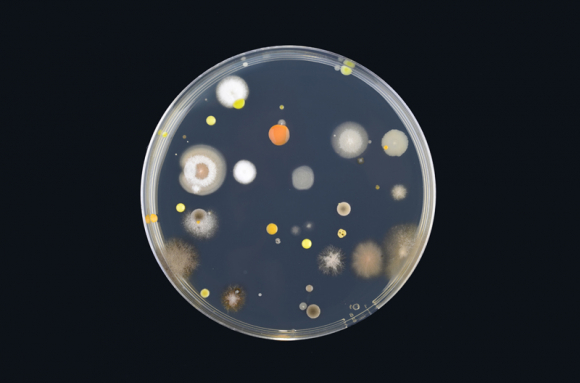
Microorganismes, alimentation et santé

La microbiologie est la science qui s’intéresse à l’étude des microorganismes, c'est-à-dire des êtres vivants de très petite taille, qui ne sont généralement visibles qu'au microscope. Il en existe de nombreuses catégories, et beaucoup d'espèces n'ont pas encore été inventoriées, mais que l'on a réparties en grandes catégories : les protozoaires (organismes animaux), les bactéries, les moisissures et levures (groupe des champignons ou fungi) et les virus.
Certains microorganismes (une minorité) sont capables de provoquer des maladies chez l’humain (l’hôte) : on les qualifie de microorganismes pathogènes. Le paludisme (ou malaria), la dysenterie amibienne sont des maladies dues à des protozoaires, la peste et le tétanos ont une origine bactérienne, les mycoses sont dues à des champignons microscopiques, et la grippe, le sida ou la variole sont engendrées par des virus.
D'autres microorganismes, au contraire, sont directement bénéfiques à l'organisme humain (microbiote du tube digestif par ex.), aux animaux (symbioses avec les protozoaires et les bactéries chez les ruminants) ou sont domestiqués et exploités par de nombreuses industries (alimentaire, pharmaceutique) ainsi que par le génie génétique. Pour assurer la fabrication du pain, des fromages, des vins et autres boissons alcoolisées, des yaourts,... l'intervention de microorganismes est incontournable, et notre alimentation serait considérablement appauvrie sans leur présence.